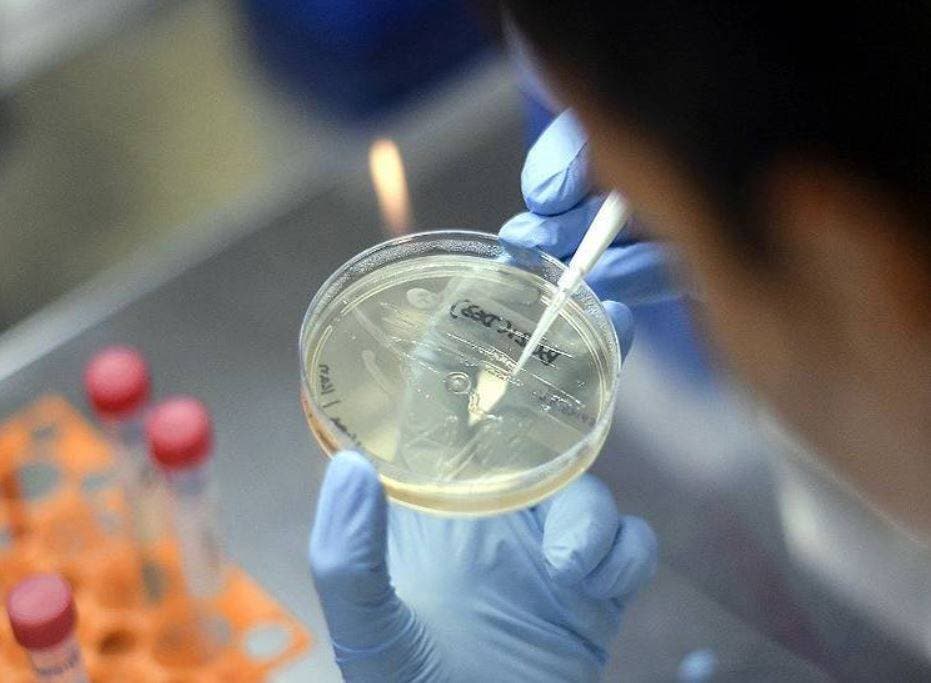
मां के दूध से बनाई जा सकती है कोरोना की एंटीबॉडी, रिसर्च में दावा

मां के दूध से बनाई जा सकती है कोरोना की एंटीबॉडी, रिसर्च में दावा
कोरोना वायरस की वजह से अब तक लाखों लोगों की मौत हो चुकी है. यही वजह है कि दुनिया भर के देश इस महामारी की दवा और वैक्सीन की खोज में दिन रात जुटे हुए हैं. विशेषज्ञों और वैज्ञानिकों की लाख कोशिशों के बाद भी अब तक इसमें कोई बड़ी सफलता हाथ नहीं लगी है. वैक्सीन बनाने के लिए नित नए प्रयोग हो रहे हैं. अब इसी क्रम में मां के दूध से भी कोरोना के इलाज का दावा किया जा रहा है.
इसी को लेकर द जर्नल ऑफ क्लिनिकल माइक्रोबायोलॉजी में शुक्रवार को प्रकाशित एक रिसर्च के अनुसार, मां के दूध से एंटीबॉडी बनाकर उसका परीक्षण किया गया है.
रिसर्च से पता चला है कि संक्रमित महिला के स्तन के दूध में कोरोना वायरस के एंटीबॉडी हो सकते हैं जो बच्चों का संक्रमण से बचाव कर सकता है. इसी वजह से संक्रमित महिलाओं को भी अपने बच्चों को कोरोना वायरस से बचाने के लिए स्तनपान जारी रखने की सलाह दी गई है.
Advertisement
शोधकर्ताओं ने दावा किया है कि दूध के माध्यम से वायरस का संचरण नहीं होता है, और दूध में निश्चित तौर पर एंटीबॉडी हो सकता है. इस अध्ययन का नेतृत्व करने वाले द इकना स्कूल ऑफ मेडिसिन के रेबेका पॉवेल ने न्यूज एजेंसी रॉयटर्स को इसकी जानकारी दी.
डॉक्टरों के मुताबिक कोरोना वायरस के संपर्क में आने के बाद कुछ बच्चों में दुर्लभ, जानलेवा लक्षण विकसित हो रहे हैं, जिसे शोधकर्ता "पीडियाट्रिक मल्टी-सिस्टम इंफ्लेमेटरी सिंड्रोम कहा जा रहा है. इसे भी संभावित रूप से कोरोना वायरस से जुड़ा लक्षण बताया जा रहा है" डॉक्टरों को बहुत छोटे बच्चों में कई विकार नजर आ रहे हैं जो उनके शारीरिक अंगों को प्रभावित कर सकते हैं.
Advertisement